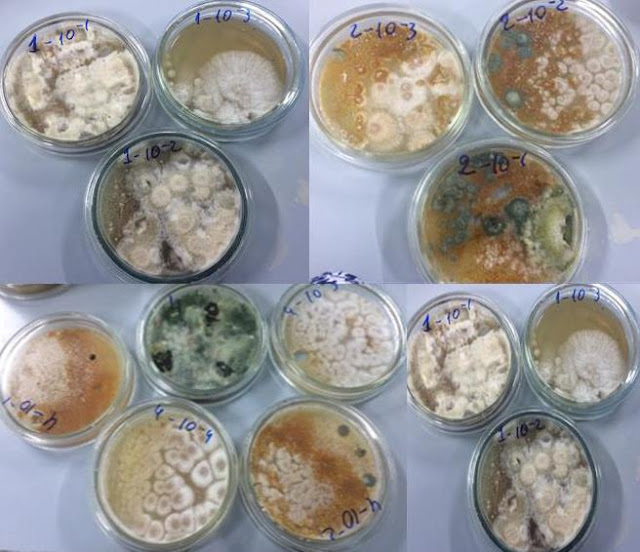

Irina Danelia , Nino
Zakariashvili , Gulnara Badridze , Lali Kutateladze , Maia Jobava , Nino
Lomidze and Ketevan Benashvili from the different institute of
the Georgia, wrote a research article about Fighting Chestnut Blight:
Antagonistic Microscopic Fungi, entitled, "Microscopic fungi
antagonistic to chestnut blight- Cryphonectria parasitica (Murrill) Barr." This
research paper published by the International Journal of Microbiology and
Micology |IJMM an open access scholarly research journal on microbiology
under the affiliation of the International Network For Natural Sciences
|INNSpub, an open access multidisciplinary research journal publisher .
Abstract
The extent of
cryphonecrosis among the chestnut populations of three Imeretian (west Georgia)
villages: Darka, Eto, and Chala has been evaluated. 23 strains of Cryphonectria
parasitica (Murrill) Barr (syn. Endothia parasitica (Murrill)
were isolated and identified from the bark of sick trees. The collection of
strains of the plant pathogen fungus has been created. The strategy of the
struggle against the chestnut blight, based on the application of antagonistic
to C. parasitica microscopic fungi, has been elaborated. For this
purpose 50 strains of different microscopic fungi were isolated and identified
(till genus) from the soil samples picked just under the stems of sick trees of
above mentioned locations. The dominating genera of micromycetes in forest
brown soils have been revealed. Strong biological antagonists of the plant
pathogenic fungus, belonging to genera Penicillium, Trichoderma and Aspergillus have
been selected on the base of the investigation of antagonistic activity of the
“aboriginal” flora of studied soils. The collection of antagonistic to C.
parasitica microscopic fungi, among them of new biological agents, has
been created. The vegetative compatibility of the isolated strains of C.
parasitica was investigated as well.
Read more : Traditional Healing:Acalypha Wilkesiana for Arterial Hypertension | InformativeBD
Reference
Wood of excellent
quality and high nutritional value fruits rise the chestnut plant - Castanea
sativa Mill. in range of popular and economicaly significant trees in the
world. (Heiniger and Rigling, 1994). Though, the plant is under the danger of
extinction all over the world. The reason of it is so called “chestnut blight”
disease caused by the plant pathogenic fungus from ascomycetes Cryphonectria
parasitica (Murrill) Barr (syn. Endothia parasitica (Murrill)) (Anagnostakis,
1994; Rigling and Prospero, 2018).
It is more than half of a century
the world scientists try efforts to fight the chestnut blight but in vain.
Healing of sick trees with hypovirulent strains is regarded to be the most
effective measure against C. parasitica today (Robin and Heiniger 2001; Puia et
al., 2012). As it has established, hypovirulence is stipulated by the existence
of Cryphonectria hypovirus (CHV) in the cytoplasm of C. parasitica. The genome
of the virus is double chain RNA molecule (ds RNA). The virus lacks of capsid,
which suppresses its active spreading in the environment. The virus is able “to
enter” a new host organism only in case of formation of the hypae anastomoses
between two stains of C. parasitica, or by means of the host’s asexual spores.
Though, wide scale integration of hypovirus under the natural conditions is not always possible because of the vegetative incompatibility of C. parasitica’s different stains (Anagnostakis, 1977). There exists another method of the biological inspection of chestnut blight: isolation of antagonistic to C. parasitica microorganisms from the natural sources and their application against the pathogen. According to literary data among the antagonistic microorganisms of C. parasitica are well known genera of microscopic fungi and bacteria (Trichoderma, Penicillium, Bacillus, Streptomyces) (Wilhelm et al., 1998; Groome et al., 2001; Akilli et al., 2011; Smith, 2013).
Combined application of antagonists and hypovirulent strains of C. parasitica appeared especially effective against the disease (Akilli et al., 2011). Those countries which are unable to control chestnut blight by hypovirulent strains, for the purpose to localize the pathogen, apply the easy way of in situ struggle against the pathogen – soil compressing or mud packing method (Anagnostakis, 1994; Groome et al., 2001).
The above mentioned botanical disaster of 20th century touched country of Geogia as well. Ten years ago 50% of Georgian chestnut forests were already dead (Prospero et al., 2013). There does not exist any effective fungicide against C. parasitica, according to the information of Georgian Ministery of Environment Protection. Cutting of sick trees is the only way of cryphonecrosis localization here. Except the joined scientific project of Swiss and Georgian investigators and attempts of the Turkish scientists of integration of hypovirulent strains in Ajara chestnut forest, practically no active measures have been performed for saving of the unique plant of Castanea sativa in Georgia, which is placed in “Georgian red list” and “Red book” (Prospero et al., 2013). Thus, elaboration and testing of the strategy of biological control against cryphonecrosis in Georgian chestnut forests is very urgent task today. Accordingly, the purpose of the presented work was to isolate the virulent strains of C. parasitica, spread in chestnut populations of one of the regions of west Georgia (Imereti), and to reveal the effective, antagonistic biological agents against them. The strategy of the fight against chestnut blight, spread in chestnut populations of west Georgian region Imereti, will be elaborated for the first time, and isolation of antagonistic to C. parasitica microscopic fungi directly from one of the hot spots of cryphonecrosis of Georgia will be performed for the first time, as well as creation of the collection of antagonists against the pathogen. All this may be regarded as the scientific novelty of the presented work.
Collection
of this type may be considered as the material base for management and
localization of chestnut blight epidemic in this region. We hope that creation
of the antinecrotic bio-preparation and its in situ testing on the base of
isolated particular antagonist microscopic fungi or their consortia will become
possible in future.
Reference
Akilli S,
Katircioğlu YZ, Maden S. 2009. Vegetative compatibility types of
Cryphonectria parasitica, causal agent of chestnut blight, in the Black Sea
region of Turkey. Forest Pathology 39(6), 390-396.
Akilli S, Katircioğlu
YZ, Maden S. 2011. Biological control of chestnut canker caused by Cryphonectria
parasitica, by antagonistic organisms and hypovirulent isolates. Turkish
Journal of Agriculture and Forestry 35(5), 515-523.
Anagnostakis SL. 1977.
Vegetative incompatibility in Endothia parasitica. Experimental Mycology
1(4), 306-316.
Anagnostakis SL. 1994.
Protecting chestnut trees from blight. Northern Nut Growers Association (USA).
Arx, von JA. 1970.
The genera of fungi sporulating in pure culture. Gramer Lehre, 1-288.
Bilaiy VI, Koval
EZ. 1988. Aspergills. Kiev, Naukova Doumka (in Russian).
Crous PW, Shivas RG,
Quaedvlieg W, Van der Bank M, Zhang Y, Summerell BA, Guarro J, Wingfield MJ,
Wood AR, Alfenas AC, Braun U. 2014. Fungal Planet.
Dugan FM. 2006.
The Identification of Fungi. An Illustrated Introduction with Keys, Glossary
and Guide to Literature. APS Press, St. Paul, MN. USA. 176.
Fomin GS, Fomin
AG. 2001. Soil. Monitoring on Quality and Ecologic Safety in Accordance
with International Standards. Moscow. VNII standard (in Russian).
Groome PC, Tattar TA,
Mount MS. 2001. Bacteria found on American chestnut bark and their
potential in biocontrol of chestnut blight. Arboricultural Journal 25(3), 221-234.
Heiniger U, Rigling
D. 1994. Biological control of chestnut blight in Europe. Annual review of
phytopathology 32(1), 581-599.
Kreisel H, Fisher G. 1969.
Grundzuge eines haturlichen systems der pilze. Jena.
Litvinov A. 1967.
Guide of microscopic soil fungi. Leningrad (in Russian).
MacDonald WL, Double ML.
2004. Hypovirulence: use and limitations as a chestnut blight biological
control. In: Restoration of American chestnut to forest lands. Proceedings
of a Conference and Workshop 7-95.
Malloch D. 1981. Moulds,
their isolation, cultivation, and identification. University of Toronto Press.
Milgroom MG, Cortesi
P. 2004. Biological control of chestnut blight with hypovirulence: a
critical analysis. Annu. Rev. Phytopathol 42, 311-338.
Pidoplichko NM, Mylko
AA. 1971. Atlas of Mucosal Fungi. Kiev, Naukova Dumka (in Russian).
Prospero S, Lutz A,
Tavadze B, Supatashvili A, Rigling D. 2013. Discovery of a new gene pool
and a high genetic diversity of the chestnut blight fungus Cryphonectria
parasitica in Caucasian Georgia. Infection, Genetics and
Evolution 20, 131-139.
Puia CE, Grogorescu DA,
Miclea RV. 2012. The Morphology and the Biological Control of
Cryphonectria parasitica. Bulletin of the University of Agricultural
Sciences & Veterinary Medicine Cluj-Napoca. Agriculture 69(1).
Rigling
D, Prospero S. 2018. Cryphonectria parasitica, the causal agent of
chestnut blight: Invasion history, population biology and disease control.
Molecular plant pathology 19(1), 7-20.
Robin C, Heiniger
U. 2001. Chestnut blight in Europe: diversity of Cryphonectria parasitica,
hypovirulence and biocontrol. Forest Snow and Landscape Research 76(3), 361-367.
Smith AR. 2013. Biological
Control of Cryphonectria Parasitica with Streptomyces and an Analysis of
Vegetative Compatibility Diversity of Cryphonectria Parasitica in Wisconsin,
USA. Doctoral dissertation, University of Wisconsin–La Crosse.
Waksman SA, Curtis
RE. 1916. The actinomyces of the soil. Soil Science 1(2), 99-134.
Warcup JH. 1950.
The soil-plate method for isolation of fungi from soil. Nature 166, 117.-118.
Wilhelm E, Arthofer W,
Schafleitner R, Krebs B. 1998. Bacillus subtilis an endophyte of chestnut
(Castanea sativa) as antagonist against chestnut blight (Cryphonectria
parasitica). Plant cell, tissue and organ culture 52(1-2), 105-108.
Zviagintsev NDG. 1980.
Methods of Soil Microbiology and Biochemistry. Moscow University, 12-14. (in
Russian).

0 comments:
Post a Comment